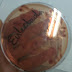

- Material que necesitamos para la práctica: Microscopio, portaobjetos, cubreobjetos, aceite de inmersión, agua destilada, levadura, azul de metileno, pipeta pasteur, vaso de precipitado, espátula, asa de siembra.
- Procedimiento: Realizamos la mezcla del agua destilada con la levadura con ayuda de la espátula en un vaso de precipitado. Cuando logramos una mezcla homogénea con ayuda del asa de siembra cogemos una muestra y la depositamos sobre un portaobjetos y colocamos un cubreobjetos encima. Realizamos su observación al microscopio con diferentes aumentos. Esperamos unos minutos para que se produzca la fermentación de la levadura y volvemos a realizar la observación al microscopio. Por último teñimos la muestra con azul de metileno y observamos la muestra una última vez al microscopio en busca de una gemación.
- Fotografías tomadas en clase de diferentes partes del procedimiento:
-Levadura utilizada para la práctica:
- Mezcla de la levadura con el agua destilada:
- Levadura observada al microscopio:
- Tinción de la levadura:
- Observación de la gemación con aceite de inmersión:

En que aumento estan las imagenes de la levadura?
ResponderEliminarque paso con la levadura antes y después de teñirla?
ResponderEliminar